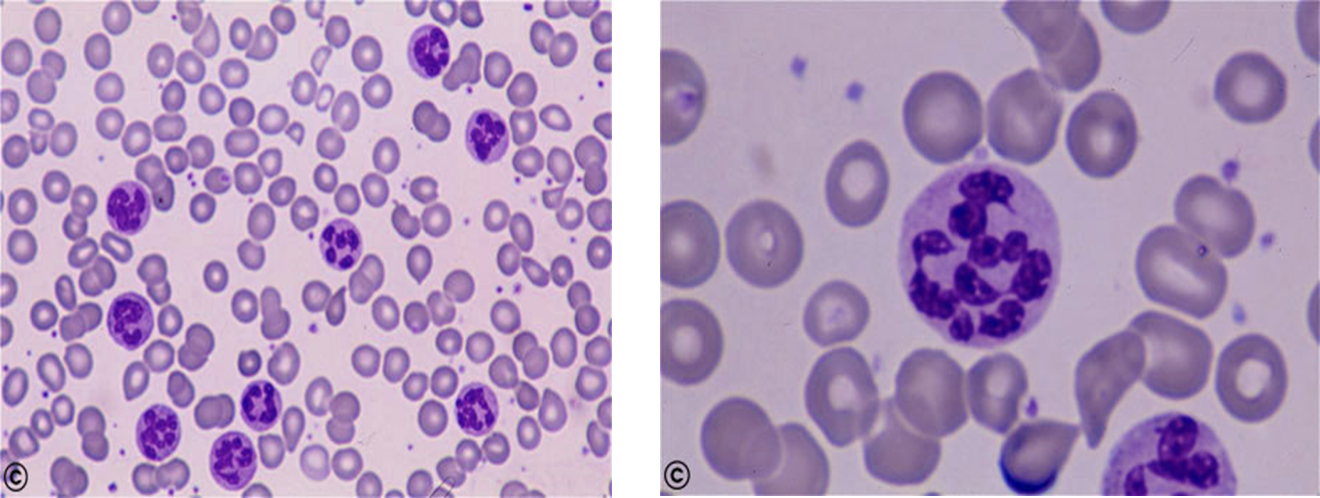
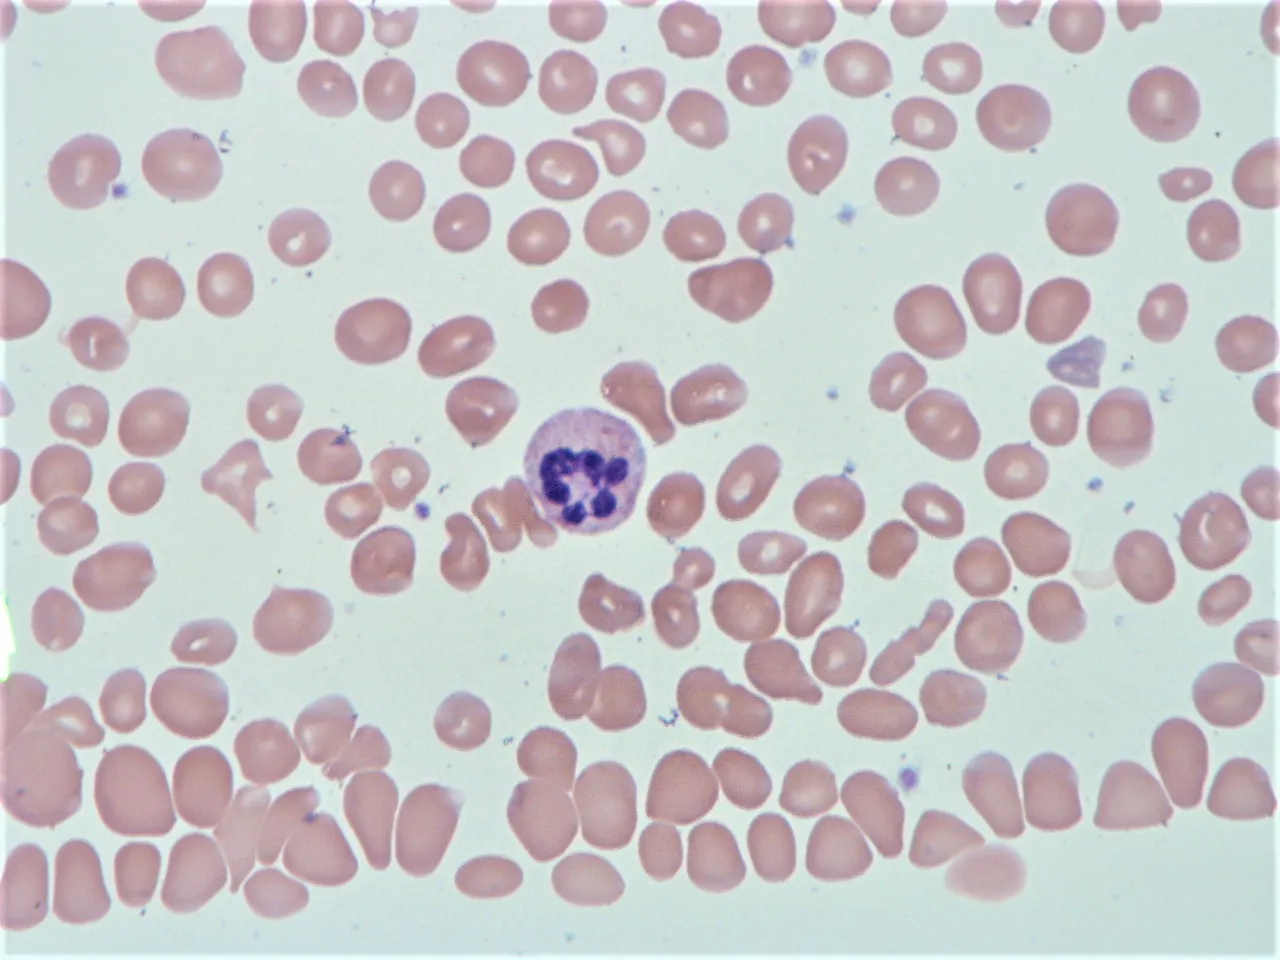

Internal Medicine
MEGALOBLASTIC ANEMIA
DR WAQAR
Megaloblastic anemia is a type of macrocytic anemia characterised by the presence of “megaloblasts” in the bone marrow, and is mostly due to Vit.B12 or Folic acid deficiency. The RBCs which enter the blood, are large (macrocytes)
“Megaloblasts” are large, abnormal cells with immature nucleus due to problem in cell maturation. WBCs & platelets are also affected.
ANEMIA
| Normocytic | Microcytic (thal) | Macrocytic (iron) |
|---|---|---|
| (normal RBC size, so norm. MCV) | (small RBC MCV low) | (big RBCs, so MCV high) ⇒ | | Megaloblastic | Non-megaloblastic |
OTHER CAUSES OF HIGH MCV
(but no megaloblasts)
- Pregnancy
- Hypothyroidism
- Drugs (azathioprine); immunosuppressants
- Liver disease
Approach
- Rule out any drug induced cause, preg., hypothyroidism
- Do peripheral smear
- Check B12 plus folate levels
- If both are low, give both
Never give folic acid alone if there is only B12 def. It will correct the anemia but neuro features will progress
Normal RBC synthesis in bone marrow

Many substances are required for this normal process of RBC synthesis.
2 things which are very important for RBC synthesis (and also for synthesis of WBC & platelets) are: a) Vitamin B12 b) Folic acid
These are required for normal maturation of cells
What happens in B12 or folic acid deficiency
- Due to deficiency of B12 or folic acid, the cells in the marrow cannot develop normally.
- This results in large abnormal cells with immature nucleus. These cells are called “megaloblasts”; bonemarrow
- Some RBC megaloblasts lose the nucleus and go in the blood as large “macrocytes.”
CAUSES OF MEGALOBLASTIC ANEMIA
- Vitamin B12 commonest causes due Pernicious Anemia
- Folic acid deficiency commonest causes
- Drugs
RAPID FIRE QUESTIONS
- Causes of microcytic anemia?
- 2 causes of megaloblastic anemia?
- What 2 things are needed for B12 absorption?
- Which foods contain B12?
- Causes of B12 def?
- Where is B12 absorbed?
- No B12 is absorbed in the duodenum, true or false?
-
Besides anemia, what else can occur in B12 def?
-
Name 3 neuro problems?
-
What will you see on peripheral smear?
-
If B12 levels are borderline, what to check next?
-
Bone marrow biopsy LAAZIM?
-
What is pernicious anemia?
-
Name the antibodies of pernicious?
-
B12 def due to gastrectomy is called pernicious anemia, true or false?
-
Best treatment for pernicious, injections or oral?
-
Patient has B12 def. What 2 medicines to give?
-
In B12 def., are neuro features reversible?
-
Food sources of folic acid?
-
Causes of folate def?
-
Can B12 def cause folate def?
-
Best test to diagnose folate def?
-
Folate def causes neuro problems, true?
-
Causes of macrocytic anemia without megaloblasts?
-
Name 1 drug which causes macrocytic anemia?
-
50 year old male. Vegetarian - TANMEEL in hands & feet since 1 month - No anemia on physical exam - CBC normal - What will you do next?
Pediatrics
Introduction
- Characterized by defective synthesis of deoxyribonucleic acid (DNA) in all proliferating cells.
- Most commonly results from lack of folic acid or vitamin B12.
- Green vegetables, fruits, and animals (e.g., liver, kidney) are major sources.
- The physiologic requirement for vitamin B12 is about 1-3 μg/day and folate is 100–200 μg/day.
Causes of Nutritional Megaloblastic Anemia
- Decreased intake: vegetarian diets as it is destroyed by cooking.
- Chronic intestinal diseases: Crohn’s disease, celiac disease.
- Drugs: like phenytoin and pyrimethamine.
- Increased demand during rapid growth: - Infancy, premature babies, adolescents. - Recovery from PEM and chronic hemolytic anemia (thalassemia, sickle cell anemia, and spherocytosis).
Clinical Features
- Pallor, failure to grow, fatigability, restlessness, and lethargy.
- Older children: sore red tongue, atrophy of papillae, angular stomatitis, glossitis, and diarrhea.
- Hyperpigmentation in knuckles of hands is diagnostic.
- Persistent chronic progressive deficiency: Mental apathy, failure to thrive, regression of milestones, and tremors.
- Vitamin B12 deficiency: degeneration and demyelination of peripheral nerve leading to peripheral neuropathy, involvement of selected column in the spinal cord, and defective cerebral function.
- Folate deficiency does not cause neuropathy.

Diagnosis
Peripheral Blood Findings
- Hemoglobin – decreased
- Hematocrit – decreased
- RBC count – decreased/normal
- MCV - >100 fl (normal 82-98 fl)
- MCH – increased
- MCHC – NORMAL
- Reticulocytes - decreased
- Total WBC count – normal/low
- Platelet count – normal/low
- Pancytopenia, especially if anemia is severe.
Peripheral Smear
- Red Blood Cells: Macrocytosis is the earliest sign in VitB12 deficiency (can be detected even before the onset of anemia).
- In severe anemia, in addition to macrocytosis, marked anisopoikilocytosis, basophilic stippling, Howell-Jolly bodies, and Cabot’s rings may be found.
- Late or intermediate erythroblast with fine, open nuclear chromatin (megaloblast) may be seen.

White Blood Cells
Normal or reduced count. Hypersegmented neutrophils is one of the earliest signs of megaloblastic hematopoiesis and can be detected even in the absence of anemia (when more than 5% of neutrophils show ≥ 5 lobes; 1% neutrophils with ≥ 6 lobes).
Platelets
- Normal or decreased (severe anemia), Giant platelets can occur.
Peripheral smear showing macro-ovalocytes and hypersegmented neutrophils
Peripheral smear showing macro-ovalocytes and hypersegmented neutrophils
Bone Marrow Examination
- Markedly hypercellular.
- Myeloid: erythroid ratio decreased or reversed. Normally, M:E ratio is 3:1. It becomes 1:1 or 1:3 reflecting erythroid hyperplasia.
- Erythropoiesis: MEGALOBLASTIC.
- Granulocytic series: Most prominent change – giant metamyelocyte with horseshoe-shaped nuclei and finer nuclear chromatin, and in band form.

Biochemical Findings
- Increase in serum unconjugated bilirubin - due to ineffective erythropoiesis.
- Increase in LDH.
- Normal serum iron and ferritin.
- Serum vitamin B12 assays.
- Methylmalonic acid and homocysteine markedly elevated in B12 deficiency.
- Schilling test, a measure of Cbl absorption, is no longer available.
- Anti–IF antibodies and anti–parietal cell antibodies are useful for the diagnosis of pernicious anemia.
- Levels of RBC folate are a better indicator of chronic deficiency. The normal RBC folate level is 150-600 ng/mL of packed cells.
Treatment
- Folic acid may be administered orally or parenterally at 0.5-1.0 mg/day. A hematologic response can be expected within 72 hours.
- Folic acid therapy should be continued for 3-4 weeks until a definite hematologic response has occurred. Maintenance therapy with a multivitamin (containing 0.2 mg of folate) is adequate.
- Very high doses of folate - Hereditary folate malabsorption.
- Vitamin B12 deficiency: Treatment with B12. Dose adjustments should be made in response to clinical status and laboratory values.
- Treatment with folate alone can produce a hematologic response in B12 deficiency, but does not correct the neurological damage caused by vitamin B12 deficiency. Thus, all megaloblastic anemias should be treated with adequate doses of both folate and vitamin B12.
- Anemia unresponsive to folate or B12 may be caused by certain metabolic disorders or antimetabolic drugs.
- Transfusions only when the anemia is severe or the child is very ill.
FM
A. Folic Acid Deficiency B. Vitamin B12 Deficiency
A- Folic Acid Deficiency
- Aetiology:
- Decrease ingestion
- Impaired absorption
- Impaired use
- Drugs: methotrexate and anticonvulsants Z
Clinical Manifestations
- Macrocytic anaemia (MCV >100), low reticulocyte count, large neutrophil with hypersegmented nucleus
Diagnosis
- Decreased serum folic acid, decreased red cell folate
Treatment
- Folic acid 2-5 mg /day for 3-4 weeks
B- Vitamin B12 (Cyanocobalamin) Deficiency
Aetiology:
-
Decrease ingestion
-
Impaired absorption
-
Impaired use
-
Decreased absorption or intake of B12, resulting in hematologic and/or neurologic abnormalities.
-
Pernicious anemia (most common): a disorder causing decreased intrinsic factor production due to autoimmune destruction of parietal cells
- Gastrectomy and atrophic gastritis can also decrease intrinsic factor production.
- Forms of malabsorption (e.g. regional enteritis, and blind loop syndrome)
- Pancreatic insufficiency
- Tapeworm infection
- Certain medications ???
Neurologic Manifestations
-
Peripheral neuropathy
-
Position sense abnormality
-
Vibratory
-
Psychiatric
-
Autonomic
-
Motor
-
Cranial nerve dysfunction
-
Sexual dysfunction
-
Possible glossitis, diarrhea, and abdominal pain
-
Anemia with Macrocytosis
-
WBCs with hypersegmented neutrophils
-
RBCs characterized by macro-ovalocytes
-
Reduced reticulocyte count, with hypercellular bone marrow
-
Possible pancytopenia
-
Low B12 level (most specific test) confirms diagnosis
-
Antibodies to intrinsic factor and parietal cells confirm the etiology as pernicious anemia.
Clinical Manifestations
Same as folic acid deficiency
Diagnosis
- Low serum Vit B12
Treatment
- Administration of vit B12 (1-5 ng/kg/day) for 2 weeks then once monthly 1 mg IM